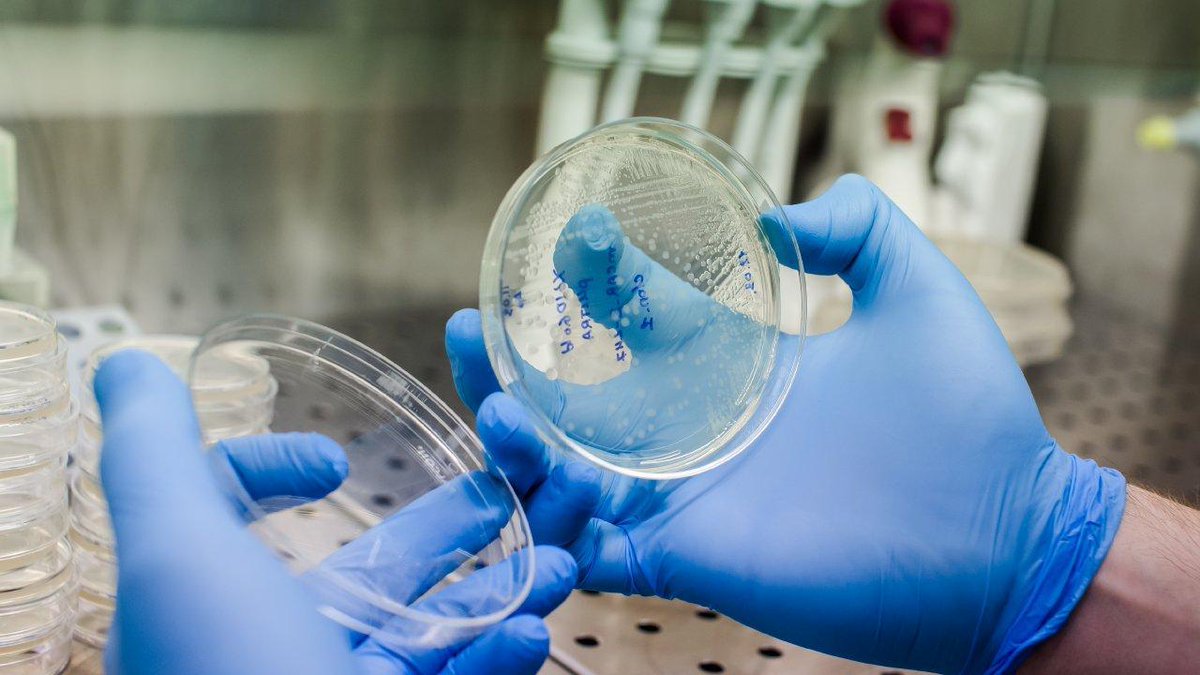

De Tijd
@tijd
Nieuws en inzicht in economie, politiek, tech en media en financiën. Hulp nodig? Contacteer @tijdhelp / Mediafin, Havenln 86C 309, 1000 Brussel, BE0404.800.301
ID: 3147651
http://www.tijd.be 01-04-2007 19:09:58
252,252K Tweet
127,127K Takipçi
165 Takip Edilen

![De Tijd (@tijd) on Twitter photo [OPINIE] De axioma's van Trumps diplomatie: profijt en kracht tijd.be/dossier/weekbo… [OPINIE] De axioma's van Trumps diplomatie: profijt en kracht tijd.be/dossier/weekbo…](https://pbs.twimg.com/media/GueIXLEWgAArJvZ.jpg)










